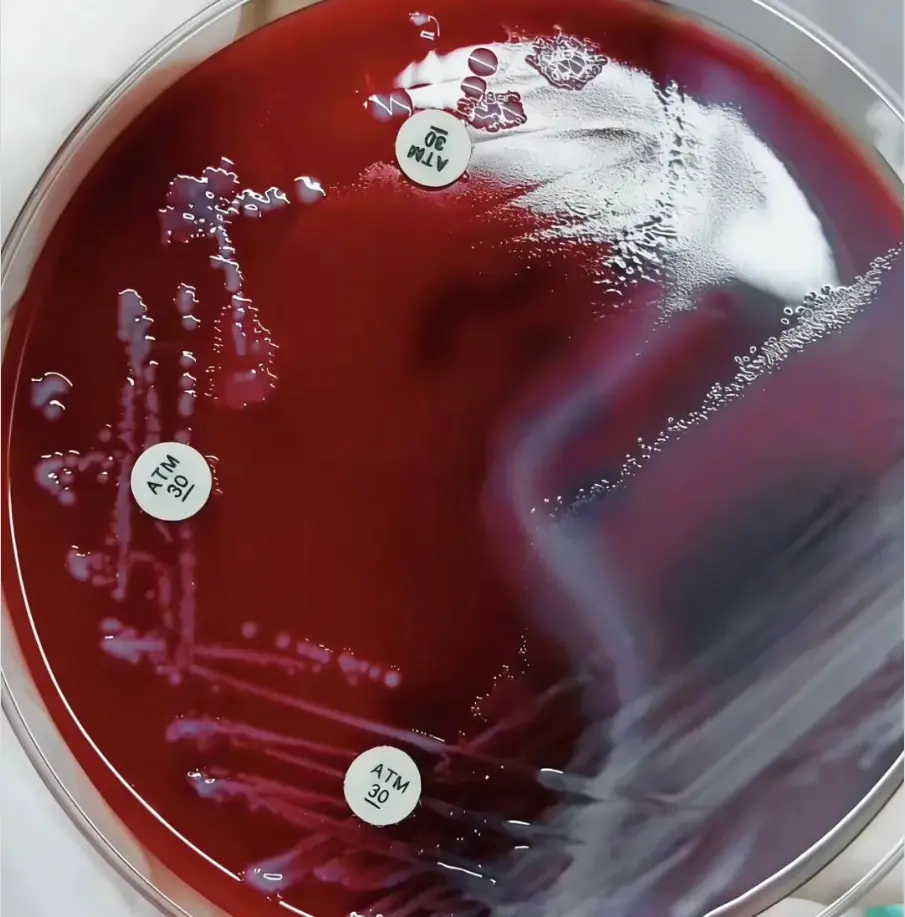
ATM(氨曲南)纸片法 ATM(氨曲南)纸片法

微生物室痛点破解:变形杆菌爬满平板?3招精准分离致病菌
发布时间:2026-04-03 浏览次数:49
各位微生物室的老师们,有没有过这种直击灵魂的崩溃:
一份临床送检的痰培养,涂片镜下明明看到了中性粒细胞内的致病菌,结果过夜培养后,血平板被变形杆菌爬得满满当当。“水漫金山”之下,目标菌株被糊得严严实实,别说单菌落了,连菌落形态都看不清,分纯鉴定更是无从下手,赶报告的节奏直接被打乱。
作为微生物室里最能“跑”的“平板恶霸”,变形杆菌的迁徙生长,绝对是无数检验人日常工作中的一大痛点。今天我们就给大家分享3个一线亲测有效的方法,轻松抑制变形杆菌迁徙,精准揪出真正的致病菌。
先搞懂:变形杆菌,到底要不要报?
首先我们要明确变形杆菌的“身份定位”:它是肠杆菌科中运动极活泼的革兰阴性杆菌,属于人体口咽部的少量正常菌群,定植能力极强。
日常工作中,绝大多数痰培养里的变形杆菌生长,都不需要报告;只有当它出现纯培养/大量生长,同时涂片见多量白细胞,再结合患者重症肺炎的临床情况时,我们才需要考虑它是致病菌。
但麻烦就麻烦在,哪怕它不是致病菌,超强的迁徙能力也会把平板上其他真正的致病菌完全覆盖,直接干扰分离鉴定流程——这也是我们必须搞定它的核心原因。
3招搞定变形杆菌,精准分离目标致病菌
1、ATM(氨曲南)纸片法——日常首选,革兰阳性菌分离神器
这是一线工作中最常用、最高效的方法,核心原理是绝大多数变形杆菌对氨曲南高度敏感,我们可以利用氨曲南的抑菌作用,把变形杆菌的迁徙生长牢牢“锁”在抑菌圈外,让圈内的目标致病菌不受干扰地长出单菌落。
适用场景:优先用于分离金黄色葡萄球菌、肺炎链球菌等革兰阳性球菌;同时可分离铜绿假单胞菌等对氨曲南耐药率较高的革兰阴性杆菌。
操作步骤:
- 接种:挑取标本中被变形杆菌覆盖的可疑致病菌菌落(小菌落可多挑取几个),在血平板上常规分区划线,注意二三区之间必须烧灼接种环,保证分离效果;
- 贴片:在平板二三区交界处贴上30μg的氨曲南药敏纸片,若标本取菌量较少,可同时在一区贴一张;
- 培养:平板置于35-37℃环境,培养18~24小时;
- 分离:培养后可清晰看到,抑菌圈外变形杆菌照常“爬满”,但抑菌圈内变形杆菌生长被完全抑制,仅对氨曲南耐药的目标菌能长出菌落,直接挑取圈内单个菌落转种纯化、鉴定即可。
实操小贴士:这个方法不止能分革兰阳性菌,我们亲测对铜绿假单胞菌的分离效果也很好——曾用这个方法,从被变形杆菌全覆盖的平板里,成功分离出了β溶血的铜绿菌株,完全不影响后续的鉴定和药敏试验。
2、SS平板转种法——革兰阴性杆菌分离专用
如果目标是分离其他肠杆菌科革兰阴性致病菌,SS平板转种法就是绝佳选择,核心原理是利用变形杆菌产硫化氢的特性,在SS平板上形成特征性菌落,与不产硫化氢的致病菌快速区分。此种方法使用较少,一般来说接种时都会接种弱选择培养基,麦康凯或中国蓝,在平板上变形杆菌的运动能力也会大大减弱,形成单独菌落。
适用场景:分离被变形杆菌覆盖的、不产硫化氢的肠杆菌科革兰阴性杆菌。
操作步骤:
直接将被变形杆菌污染的可疑菌落,转种到SS平板上,35-37℃培养18~24小时后观察菌落形态:变形杆菌在SS平板上的菌落较扁平,有明显的黑色中心;而其他不产硫化氢的肠杆菌科细菌,不会出现黑色中心,两者形态差异极大,极易区分,直接挑取目标菌落转种即可。
实操小贴士:SS平板本身是强选择性培养基,对变形杆菌的迁徙生长也有一定抑制作用,不会出现血平板上“爬满全板”的情况,更方便观察和挑取菌落。
3、无水乙醇预处理法——重污染标本的“杀手锏”
如果遇到变形杆菌污染特别严重,平板已经完全被爬满、根本找不到可疑菌落的情况,就可以试试这个无水乙醇预处理法,从源头抑制变形杆菌的生长。
适用场景:变形杆菌严重污染、完全覆盖目标致病菌的标本。
操作步骤:
- 预处理平板:取2mL无水乙醇加入空白血平板中,盖上培养皿盖,浸泡30分钟;
- 晾干平板:倒掉平板内多余的无水乙醇,将平板置于生物安全柜内,开盖彻底晾干;
- 接种培养:将待分离的标本在预处理后的血平板上分区划线接种,35-37℃培养24小时;
- 分离鉴定:直接挑取平板上长出的单个菌落,进行转种纯化和鉴定即可。
实操小贴士:划重点!无水乙醇属于易燃易爆危险品,整个操作过程必须在生物安全柜内进行,严格远离明火和热源;同时平板一定要彻底晾干,否则残留的乙醇会抑制所有细菌的生长,反而达不到分离效果。
总结如下:

以上就是今天给大家分享的3个应对变形杆菌迁徙、分离致病菌的实用方法,都是一线工作中亲测有效的干货,大家可以根据标本情况按需选用。
当然,对付这个“平板恶霸”,肯定还有更多好用的小妙招。你平时在工作中,还有什么抑制变形杆菌迁徙的独家技巧?欢迎在评论区留言分享,我们一起交流进步!
本文由环凯转载自“检言验语”公众号,版权归原作者所有,仅供学习参考,如有侵权请联系删除!
